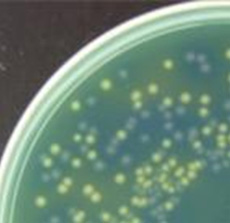

|
 |
|
Overlapping colonies can be automatically split for individual count. |
||
 |
Any kind of spiral plater can be used by changing the area freely. |
|
Standard software includes spiral plate measurement function. |
||
 |
 |
|
Due to this function, it enables to count without large expanded colonies. |
||
 |
 |
 |
||
Even if the thickness of culture medium is not uniform, the brightness can be adjusted and measured with high accuracy. |
||||
|
 |
|
Up to four colors of colonies can be measured separately. |
||
 |
The area of large expanded colonies could be deleted. |
 |
It is possible to save the contents of operations/measurements and processes in chronological order, and demonstrate that the reliability, safety, efficiency, and effectiveness of the system are ensured. |
 |
The system can be validated and the result can be judged automatically. |
| Functions | Detailed contents |
|---|---|
| Measurement result indicator | Number of viable colonies, CFU and diameter of measurement area |
| Binarization methods selection | Automatic and manual binarization, color extraction, up to 8 classes. |
| Preprocessing for binarization | Adjustment of uneven brightness (in case of uneven thickness of culture medium) Monochrome Conversion (R, G, B, or gray scale) |
| Image processing | Morphological transformation of binarized colonies, such as dilation, erosion, and hole filling. |
| Selection by size | Decide the range of target colony depending on size. |
| Selection by circularity | Possible to exclude linear dust, medium scratches, etc., depending on the circularity. |
| Overlap differentiation | Automatically separate and measure overlapping colonies. |
| Save conditions | Save process for each colony specimen recipe. |
| Count exclusion | Automatically remove large expanded colonies such like molds from the measurement areawith a preset. The area value can also be corrected. |
| Manual correction | Add or delete colonies, or except an area for count can be carried out by mouse operation. |
| Count marks | Small colonies can be checked by showing or hiding count marks on images. |
| Sector plate count | A petri dish can be divided to up to 8 parts. Any part can be excluded or measured. |
| Dilution series count | Possible to measure petri dishes with different dilution ratios and add up the CFU. |
| Spiral plate counting | Counts the number of colonies on spiral plate.A wide range of spiral platers are supported. |
| Ring plate count | Six concentric areas are measured. The diameter of each concentric circle can be arbitrarily set. |
| Multi-well plate count (optional) | Individual automatic count of each well in 6, 12, or 24-well plates. |
| OPKA (optional) | Software for Opsonophagocytic Killing Assay. Individually count the number of colonies in up to 48 areas. |
| Zone measure (optional) | Support the method of Japanese Pharmacopoeia and Latin square method. Up to 36 zones can be measured. |
| MIC test strips (optional) | Possible to judge the test results |
| Image saving | Original,binary and result images. Each image with or without counting marks. |
| Data output/ saving | Output to Excel sheet/ save in CSV, PDF or TXT formats. |
| Recalculation | Recalculation by retrieving saved images |
| Account management | Available to set accountpermissions. |
| Audit trail | Operation history can be saved. |
We will exhibit Automatic colony counters and Dish handler at Iterphex week Tokyo 2026. From 20 to 22, May 2026.
Makuhari Messe Hall 2. Stand No. 6-28.